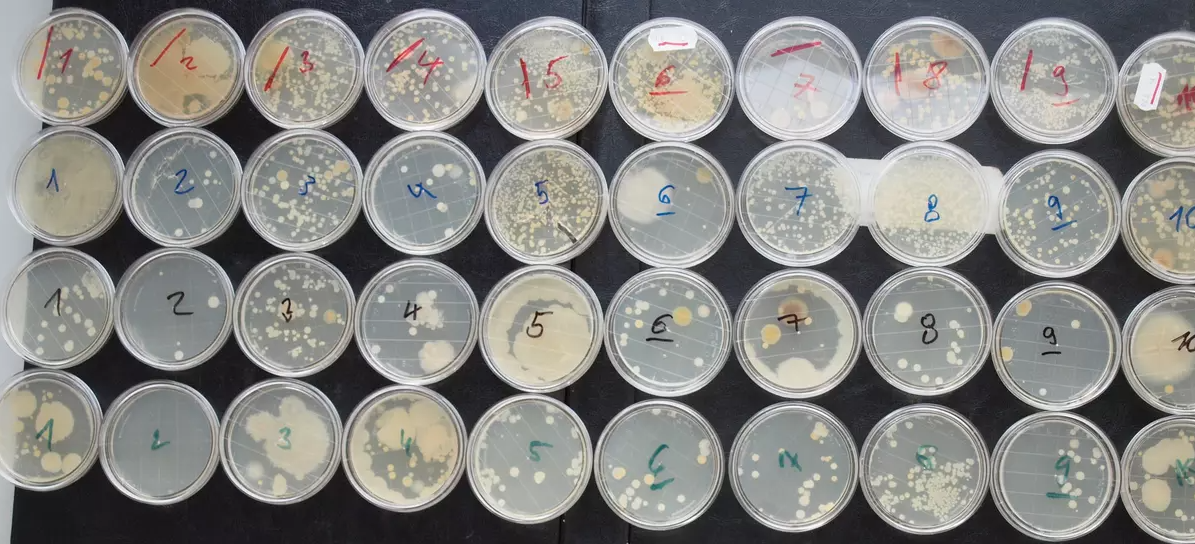

Umělý virus

Koronavirus vytvořili ve Wu-chanu, tvrdí hongkongská viroložka. Brzy prý dodá důkazy
Hongkongská viroložka Li-Meng Yan tvrdí, že koronavirus SARS CoV-2 pochází z čínské laboratoře a že brzy zveřejní o svém tvrzení důkazy. Řekla to v britské talk show Loose Women komerční televize ITV. Yan ze strachu před čínskými úřady z Hongkongu uprchla a nyní se ukrývá na neznámém místě v USA.
Viroložka a imunoložka, která před svým útěkem působila na School of Public Health v Hongkongu tvrdí, že nový typ koronaviru je lidským výtvorem a že čínská vláda o něm věděla mnohem dříve, než se informace dostaly na veřejnost. Podle ní jsou tvrzení o tom, že virus vznikl na mokrém tržišti ve Wu-chanu, pouze krycím manévrem. Kvůli svým tvrzením musela opustit území Hongkongu, neboť se prý bála o život.
Yan tvrdí, že brzy zveřejní zprávu, z níž bude patrné, že SARS CoV-2 je lidským výtvorem a že má důkazy, díky nimž to pochopí a budou si moci ověřit i laici. "Kdokoliv, i bez elementární znalosti biologie, bude schopen si to přečíst a ověřit zcela sám," ujistila. Její předchozí výzkumná data prý Čína vymazala z vládních databází.
"Pracovala jsem s největšími světovými experty, a jelikož mám dva tituly z pevninské Číny, pověřili mě účastí na tajném výzkumu o nové respirační chorobě ve Wu-chanu. Na co jsem během výzkumu přišla, jsem sdělila svému supervizorovi, ale všichni měli strach,"

Americká zpráva od rozvědky identifikovala 3 výzkumníky laboratoře wuhan, kteří onemocněli v listopadu 2019

"Americká vláda se domnívá, že několik výzkumníků uvnitř WIV onemocnělo na podzim 2019, tedy ještě před prvním zjištěným případem epidemie, s příznaky, které odpovídají jak Covid-19. To vyvolává otázky ohledně důvěryhodnosti veřejného tvrzení vedoucího výzkumného pracovníka WIV Shi Zhengliho.
Nové detaily, o nichž jako první informoval the Wall Street Journal , přidávají do příběhu nepřímé důkazy , které podporují hypotézu, že se virus Covid-19 mohl rozšířit na člověka poté , co unikl z čínské výzkumné laboratoře ve Wu-chanu.
Reklamní kampaň k očkování proti covidu-19 má být v televizích, rádiích, novinách, na webech i na billboarech. Ministerstvo objedná mediální prostor za 50 milionů korun včetně DPH.
Pokračující výplach mozků se začíná uplatňovat při prodeji vakcín. Není podstatné jak dlouho po očkování vydrží imunita organizmu proti Covidu, ani není důležité zda je očkovaný infekční nebo ne. Zásadní je vpravit do organizmu člověka umělý lektvar s neověřenými účinky. Je otázkou, zda jsou skutečně neověřené, nebo snad mají utajované účinky hlubší význam?
Oni říkají, že to jediné, co nás zachrání, je vakcína. Vláda, média a celebrity používají strach, aby vás přinutili do něčeho, o čem si nemusíte být jistí. Očekávají, že si vyhrnete rukáv a uděláte něco svému tělu, co nelze odčinit.
A co dlouhodobé účinky, které se přenáší z rodičů na děti? Nikdo neví. Jelikož tyto injekce některé lidi dělají nemocnými, není divu, že generální ředitelé, co vyrábí tyto experimentální injekce, získali od vlády naprosté zproštění odpovědnosti za škody skrze něco s názvem PREP Act. To znamená, že když dostanete vakcínu a ta vás poškodí nebo zabije, výrobce té vakcíny nelze hnát k zodpovědnosti. Proč tedy tato vakcína dělá lidi nemocnými?
Pfizerova verze covid injekce obsahuje celou řadu experimentálních a průmyslových chemikálií včetně ALC-0315, což je kladně nabitá molekula, která pomáhá formovat nanočástice. Také obsahují něco s názvem DSPC a chlorid draselný. Jednosytný fosforečnan draselný. Chlorid sodný a dvojsytný dehydratovaný fosforečnan sodný. Některé tyto látky můžete najít v seznamu ingrediencí svého oblíbeného hnojiva.
Tak stojí vyplašené ovce ve frontě na aplikaci podivného patoku, který považují nejméně za elixír mládí, protože jim to státní propaganda naroubovala do hlav. Jsou dokonce i takoví nešťastníci, kteří se těší, kdy už z nich konečně budou ty mikrochiméry s laboratorně deformovanou DNA.

Roušky jsou potencionálně infekční odpad - nepodceňujme to.
Z jistého úhlu pohledu se jedná o nebezpečný infekční odpad.
Roušky neponechávejte doma povalovat. Zejména máte-li děti.
Roušky nevhazujte volně do odpadkového koše nebo do veřejných odpadkových košů.
Roušky vkládejte do dobře uzavíratelného plastového pytle. Doporučuje se vkládat do pytlů dvou, co nejpečlivěji uzavřít, a jejich povrch následně vydesinfikovat, stejně jako ruce.
Ministerstvo zdravotnictví doporučuje: Likvidace roušek, filtrů (kapesníků) od osob, se doporučuje vložit do plastového (igelitového) pytle, který se zaváže, poté se plastový pytel vloží do druhého plastového pytle, který se zaváže, povrch vnějšího pytle by měl být ošetřen dezinfekčním prostředkem, takto zajištěný odpad se doporučuje vložit do sběrných nádob komunálního odpadu až po 48 hodinách po jeho uzavření.
Za infekční odpad je nutné považovat odpad, který obsahuje životaschopné mikroorganismy
nebo jejich toxiny, o nichž je známo nebo lze spolehlivě předpokládat, že způsobují
onemocnění člověka nebo jiných živých organismů. Tento odpad musí být označen a
shromažďován odděleně od jiného odpadu, do uzavíratelných a spalitelných obalů s pevnou
stěnou bez další manipulace s ním.
"Je to nesmysl," řekl tehdy Prymula o nošení roušek na veřejnosti. "Naopak manipulace s rouškou vede k většímu riziku - ulpí na ní bacily a ty se při jejím sundávání snáze dostanou na ruce. Proto bych spíše doporučil časté a důkladné mytí rukou," říkal tehdy.
Testované roušky
10 ks látkové správně nošené - červeně popsané misky
10 ks látkové špatně nošené - modře popsané misky
10 ks jednorázové správně nošené - černě popsané misky
10 ks jednorázové špatně nošené - zeleně popsané misky
Test ale odhalil také různé sporulující bakterie, například Bacillus, nebo Staphylococcus epidermidis, které můžou způsobit onemocnění. Z plísní jsou ve vzorcích patrné Penicillium, Mucor, Cladosporium nebo Aspergillus.
Noste roušky a respirátory
to si pošmáknete

Obrázek z praxe. Prodavačky potravin si nasadí roušku vždy když do obchodu někdo přijde. To znamená, že se ve svých rukavicích nebo i bez nich neustále dotýkají infekčního odpadu na svém obličeji. Nato manipulují s penězi a s potravinami. Důsledkem je, že ten jejich humus z infekčních roušek si donesete domů v přesvědčení jak jste vyzráli na Covid. A ve skutečnosti jste si načepovali do lednice pořádný blivajs.


